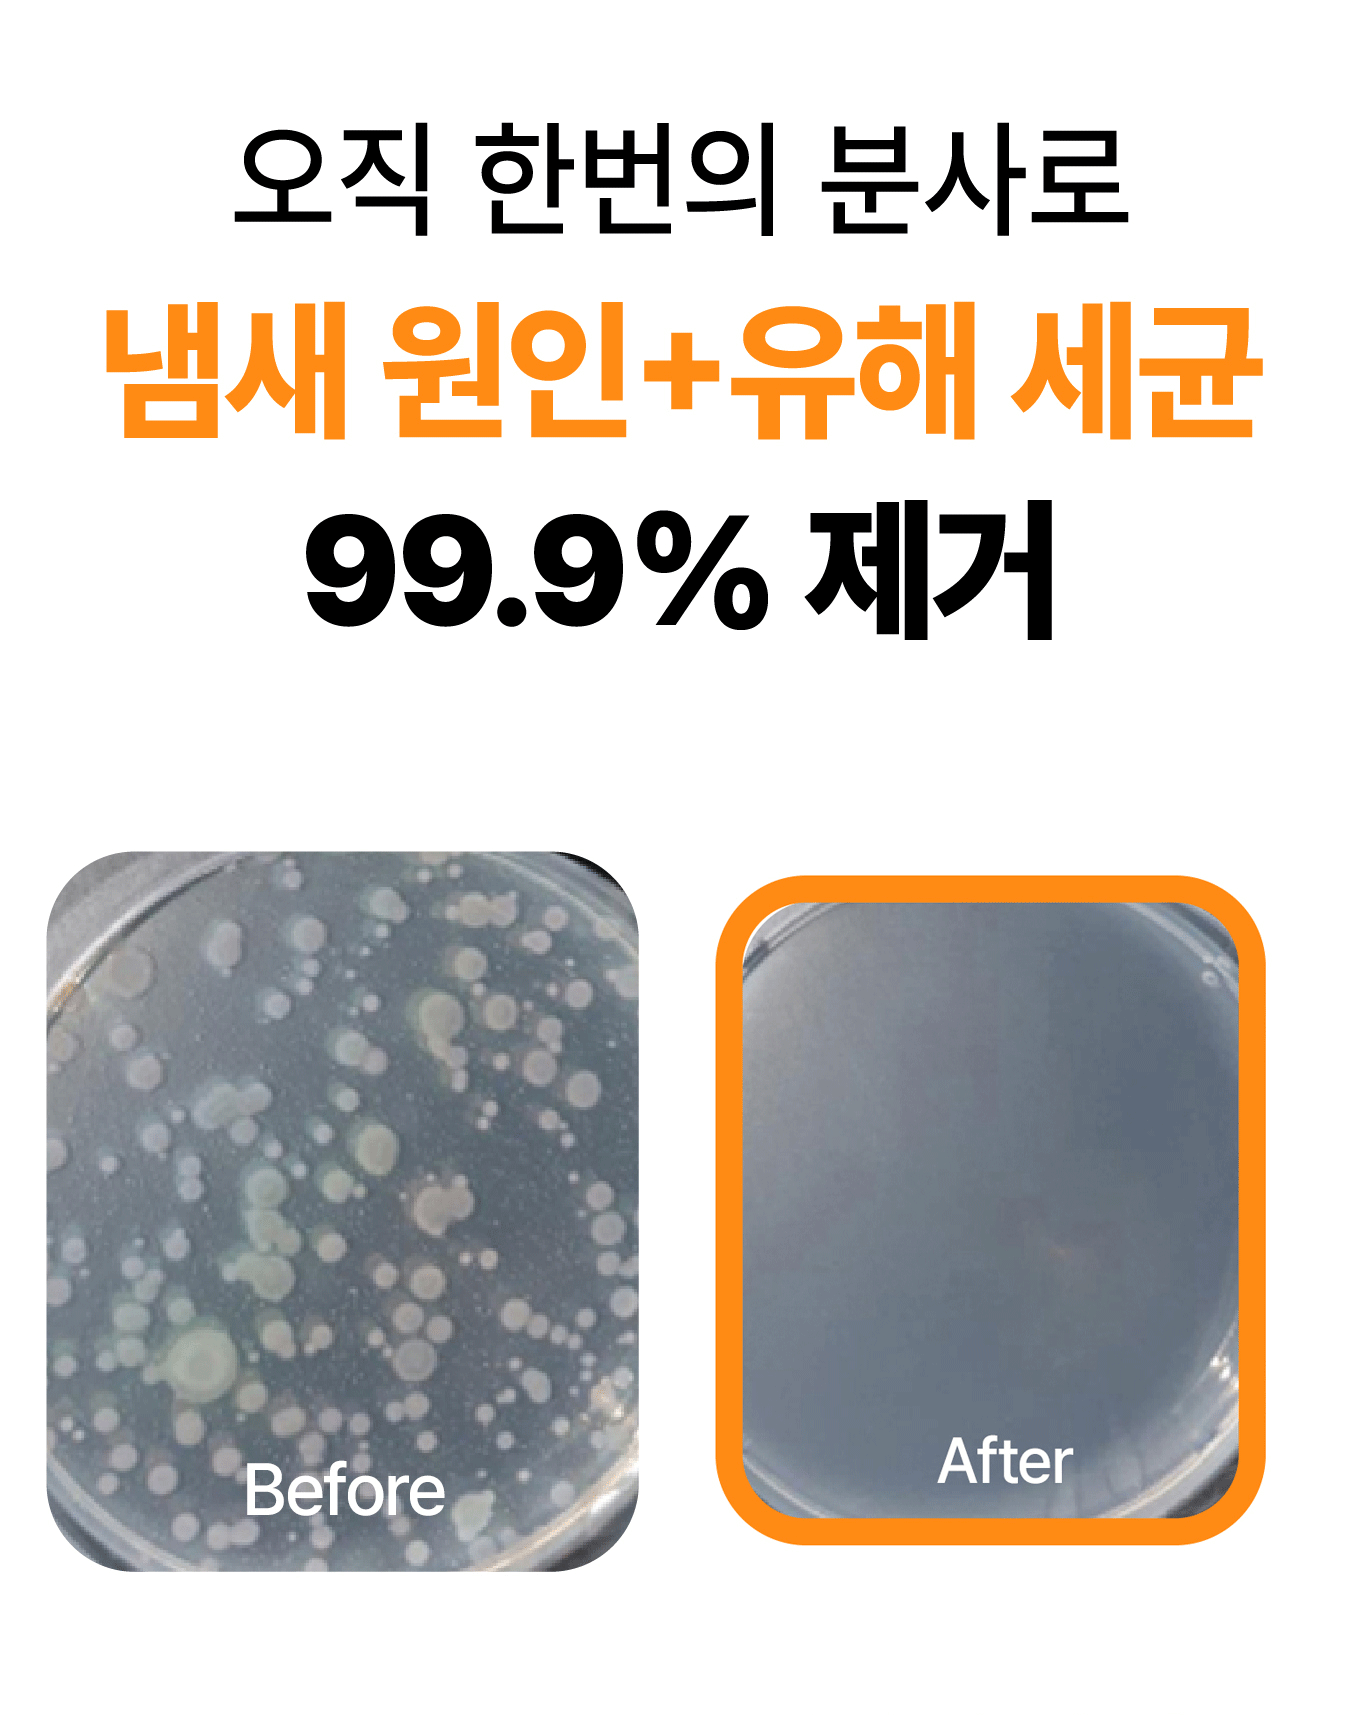
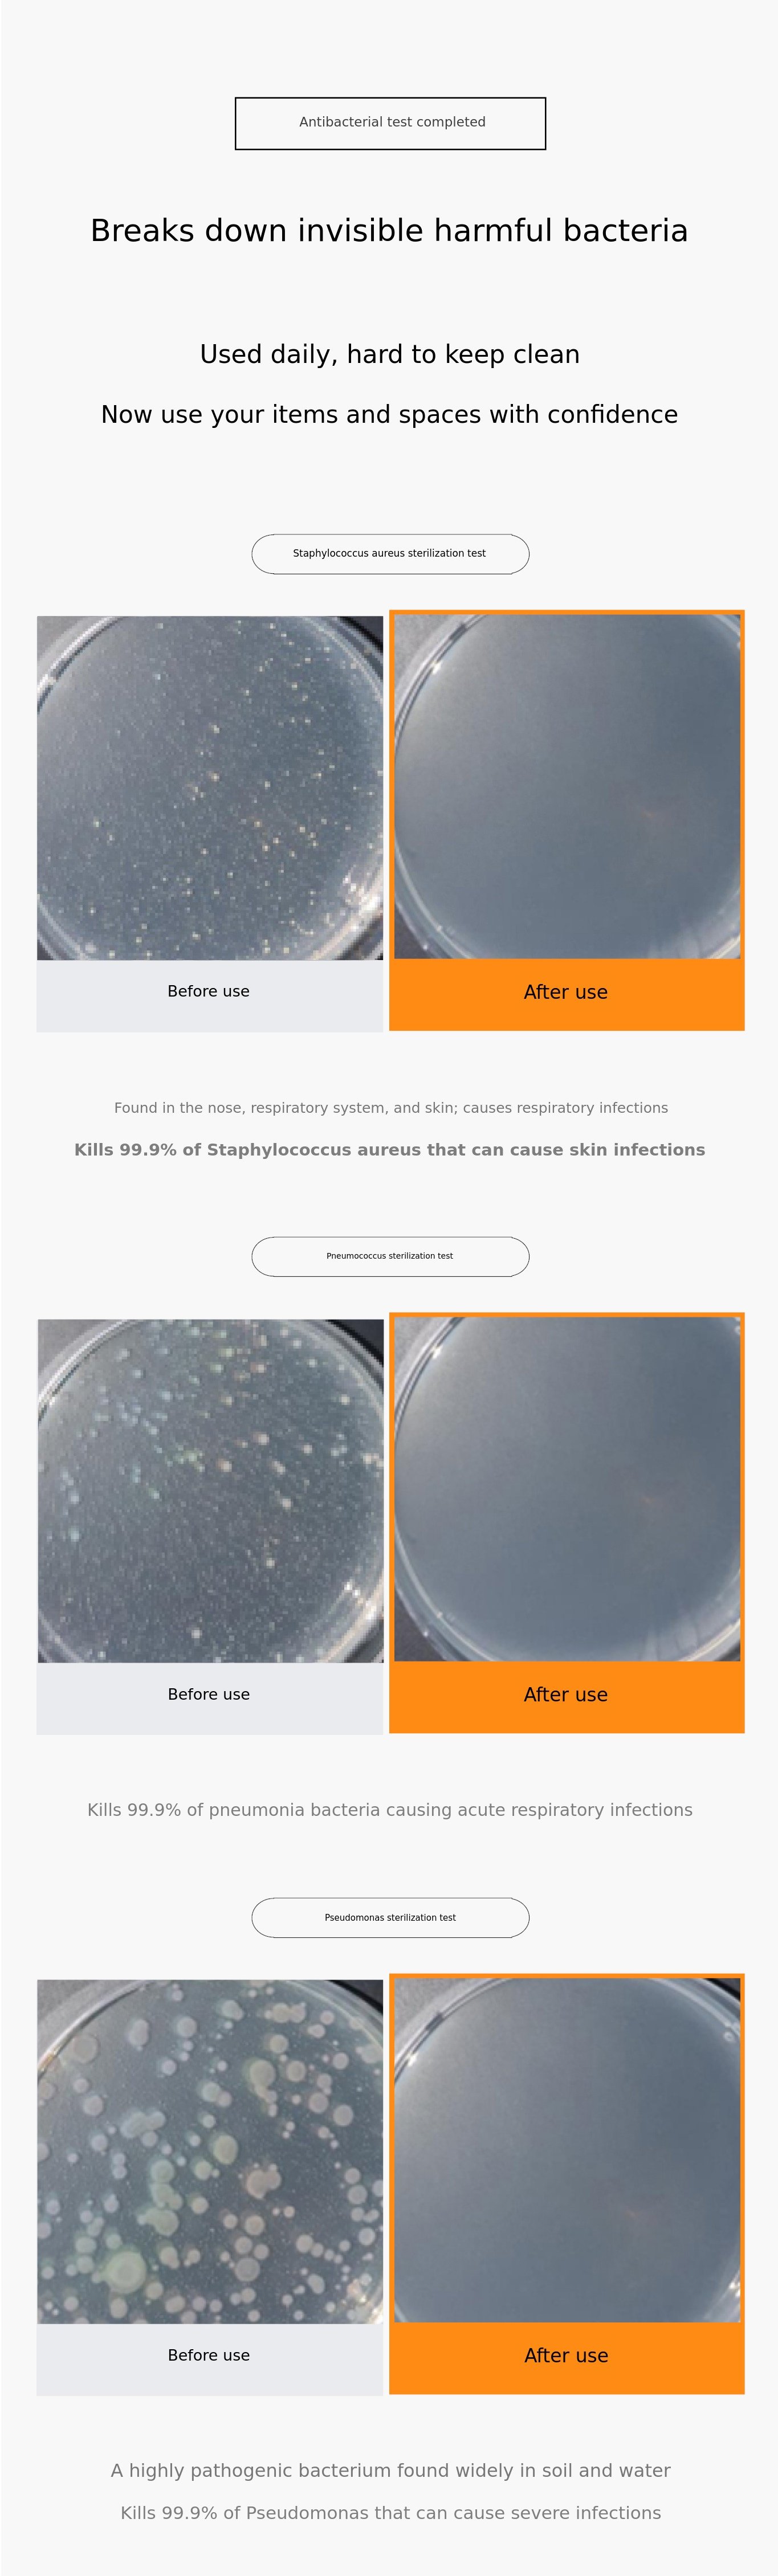

Plan for Use of Success Funds
Monthly121 will use the success funds for new product development.
WHY WADIZ?
We are developing our products and growing together through close communication with our supporters. All products from Monthly121 are always introduced first to Wadiz supporters, and we continuously improve them based on your valuable feedback. We promise to continue to reward you with even better products through close communication. We will always do our best on this journey together.
Return Policy and Exchange/A/S Policy
• Exchanges, returns, or refunds are not possible if the product is damaged due to supporter negligence or if the box is opened.
• Exchanges are not possible for products that have passed the 7-day exchange and refund period.
• For exchange requests, please contact us via Wadiz message or the CS Center at 070.7178.8899.
• All other matters follow the Wadiz operating policy.
Shipping Method
• Sequential shipping via Hanjin Courier
• For islands and mountainous areas, please add an additional 3,000 KRW for shipping when funding.
• For shipping inquiries, KakaoTalk Plus Friend: Monthly121
*Inquiries are available on weekdays from 10:00 to 17:00.
 monthly121
monthly121
